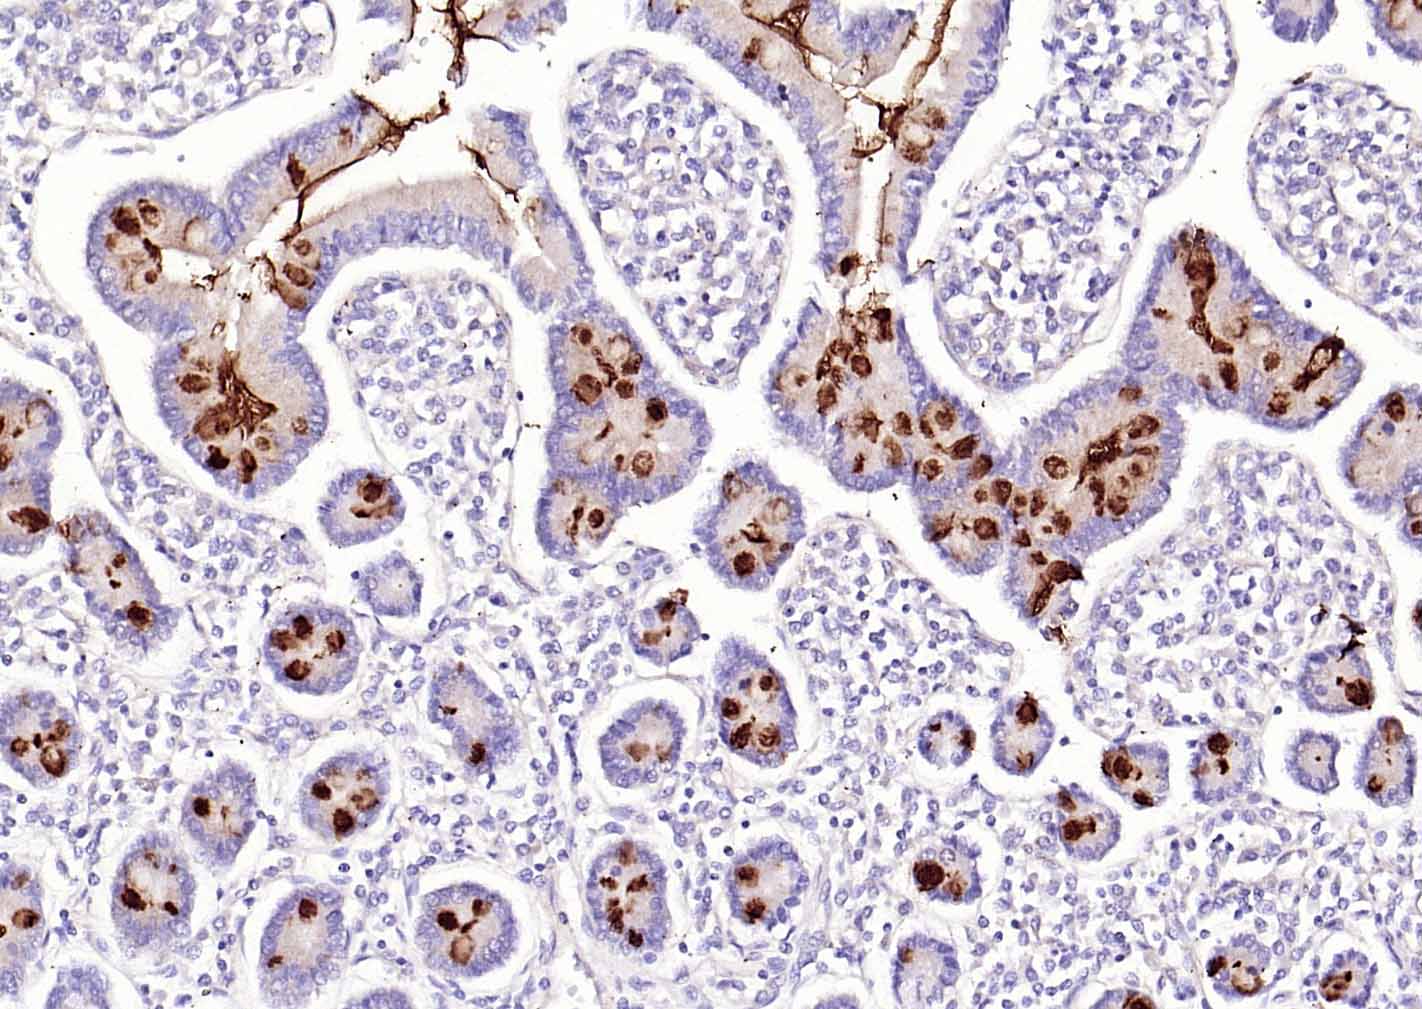
MUC2 Rabbit pAb(bs-60331R)-50u

相关产品推荐更多 >

beta I Tubulin Mouse mAb, FITC conjugated(bsm-33041M-FITC)-100ul
¥2980
NEU2 Rabbit pAb, HRP conjugated(bs-24004R-HRP)-100ul
¥2980
phospho-PKM2 (Tyr148) Rabbit pAb, PE-Cy7 conjugated(bs-20036R-PE-Cy7)-100ul
¥2980
ID1 Rabbit pAb, BF594 conjugated(bs-6541R-BF594)-100ul
¥2980
Anti-human TNFSF11 / RANKL / CD254 (Denosumab Biosimilar)(BIO0255SM)-1mg/5mg/20mg
¥1550
万千商家帮你免费找货
0 人在求购买到急需产品
- 详细信息
- 文献和实验
- 技术资料
- 应用范围:
产品信息以Bioss网站为准
- 规格:
50ul/100ul
| 规格: | 50ul | 产品价格: | ¥1580.0 |
|---|---|---|---|
| 规格: | 100ul | 产品价格: | ¥2500.0 |
| 产品编号 | bs-60331R |
| 英文名称 | MUC2 Rabbit pAb |
| 中文名称 | 粘蛋白-2/上皮膜抗原2抗体 |
| 英文别名 | MLP; SMUC; Intestinal mucin 2; MUC 2; MUC2; Mucin 2; Mucin 2 intestinal; Mucin 2 intestinal/tracheal; Mucin 2 oligomeric mucus/gel forming; Mucin 2 precursor; Mucin 2 tracheal; Mucin like protein; Intestinal mucin-2; MUC-2; MUC2_HUMAN; Mucin-2; Mucin2. |
| 产品应用 | IHC-P=1:50-200, IHC-F=1:50-200, ICC/IF=1:50-200, IF=1:50-200, WB=1:500-2000 Not yet tested in other applications. |
| 交叉反应 | Human, colon, colon, colon, colon, Human duodenum, Human duodenum, Human duodenum, Human duodenum |
| 抗体来源 | Rabbit |
| 免疫原 | KLH conjugated synthetic peptide derived from human MUC2 |
| 亚型 | IgG |
| 性状 | Liquid |
| 纯化方法 | affinity purified by Protein A |
| 克隆类型 | Polyclonal |
| 理论分子量 | 570 kDa |
| 浓度 | 1mg/ml |
| 储存液 | 0.01M TBS (pH7.4) with 1% BSA, 0.02% Proclin300 and 50% Glycerol. |
| 研究领域 | Cancer > Invasion/microenvironment > ECM > Extracellular matrix > MUC Cancer > Tumor immunology > Tumor-associated antigens Signal Transduction > Cytoskeleton / ECM > Extracellular Matrix > ECM Proteins > MUC Tags & Cell Markers > Cell Type Markers > Tumor Associated |
| 亚基 | Homotrimer; disulfide-linked. Dimerizes in the endoplasmic reticulum via its C-terminal region and polymerizes via its N-terminal region by disulfide-linked trimerization. Interacts with FCGBP. Interacts with AGR2; disulfide-linked. |
| 亚细胞定位 | Secreted. Note=In the intestine, secreted into the inner and outer mucus layers. |
| 组织特异性 | Colon, small intestine, colonic tumors, bronchus, cervix and gall bladder. |
| 翻译后修饰 | O-glycosylated.
May undergo proteolytic cleavage in the outer mucus layer of the colon, contributing to the expanded volume and loose nature of this layer which allows for bacterial colonization in contrast to the inner mucus layer which is dense and devoid of bacteria. At low pH of 6 and under, undergoes autocatalytic cleavage in vitro in the N-terminal region of the fourth VWD domain. It is likely that this also occurs in vivo and is triggered by the low pH of the late secretory pathway. |
| 相似性 | Contains 1 CTCK (C-terminal cystine knot-like) domain.
Contains 1 TIL (trypsin inhibitory-like) domain. Contains 2 VWFC domains. |
| 功能 | Coats the epithelia of the intestines, airways, and other mucus membrane-containing organs. Thought to provide a protective, lubricating barrier against particles and infectious agents at mucosal surfaces. Major constituent of both the inner and outer mucus layers of the colon and may play a role in excluding bacteria from the inner mucus layer. |
| 保存条件 | Shipped at 4℃. Store at -20℃ for one year. Avoid repeated freeze/thaw cycles. |
| 注意事项 | This product as supplied is intended for research use only, not for use in human, therapeutic or diagnostic applications. |
| 背景资料 | This gene encodes a member of the mucin protein family. Mucins are high molecular weight glycoproteins produced by many epithelial tissues. The protein encoded by this gene is secreted and forms an insoluble mucous barrier that protects the gut lumen. The protein polymerizes into a gel of which 80% is composed of oligosaccharide side chains by weight. The protein features a central domain containing tandem repeats rich in threonine and proline that varies between 50 and 115 copies in different individuals. Alternatively spliced transcript variants of this gene have been described, but their full-length nature is not known. [provided by RefSeq, Jul 2008] |
| 应用 | 推荐稀释比例 |
| {IHC-P} | {1:50-200} |
| {IHC-F} | {1:50-200} |
| {ICC/IF} | {1:50-200} |
| {IF} | {1:50-200} |
| {WB} | {1:500-2000} |

风险提示:丁香通仅作为第三方平台,为商家信息发布提供平台空间。用户咨询产品时请注意保护个人信息及财产安全,合理判断,谨慎选购商品,商家和用户对交易行为负责。对于医疗器械类产品,请先查证核实企业经营资质和医疗器械产品注册证情况。
 文献和实验
文献和实验[IF={{ 5.561 }}] {Qianqian Yao. et al. The Milk Active Ingredient, 2′-Fucosyllactose, Inhibits Inflammation and Promotes MUC2 Secretion in LS174T Goblet Cells In Vitro. FOODS. 2023 Jan;12(1):186} {IF} {Human}
[IF={{ 3.337 }}] {Wang, Chengyao. et al. Causative Role of Anoxic Environment in Bacterial Regulation of Human Intestinal Function. CELL MOL BIOENG. 2022 Sep;:1-12} {IF} {Human}
[IF={{ 3 }}] {Pan Hang. et al. Curcumin attenuates aflatoxin B1-induced ileum injury in ducks by inhibiting NLRP3 inflammasome and regulating TLR4/NF-κB signaling pathway. MYCOTOXIN RES. 2024 Feb;:1-14} {IF} {Duck}
[IF={{ 2.3 }}] {Le Zhang. et al. Intestinal stem cell-derived extracellular vesicles ameliorate necrotizing enterocolitis injury. MOL CELL PROBE. 2025 Feb;79:101997} {IF} {Mouse}
 技术资料
技术资料暂无技术资料 索取技术资料





